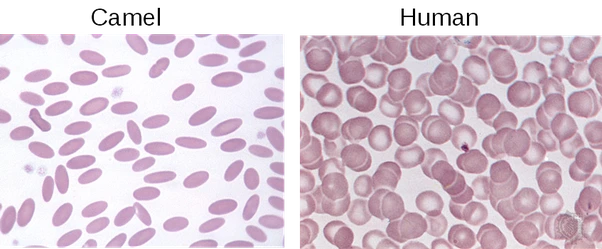

(41) 힘든가요, 숨이 턱까지 찼나요 (1)
인간의 달리기: 사냥부터 마라톤까지
by
Feb 5. 2023
어머니께서는 앞으로 나아가기 위해서는 과거는 뒤에 두어야 한다고 하셨죠. 제 달리기는 그게 전부였던 것 같네요.
-포레스트 검프 중
들어가며: 보잘것없는 인간?
동물의 세계에서, 인간의 운동 능력은 어떨까? 몇몇 송골매는 시속 400킬로미터의 속도로 비행할 수 있고(낙하하며), 치타도 시속 100킬로미터가량의 속도를 낸다(커버 사진). 쿠거는 6미터를 뛰어오를 수 있고(인간의 맨 몸 세계기록은 2.45m이다), 고릴라는 수백 킬로그램을 가볍게 들고 인간의 두개골을 한 번에 파괴할 수 있는 괴력을 가지고 있으며, 낙타는 인간이 5%의 수분을 잃으면 심각한 탈수 증상을 보이는 반면 뜨거운 태양 아래서 40%의 수분 손실도 버틸 수 있다(미주 1). 하마는 거대한 턱을 이용해 1만 3천 킬로파스칼의 압력으로 먹이를 씹을 수 있다(당신의 손톱만한 영역에 130킬로그램이 가해지는 압력이다-인간을 두 동강 내기에 충분한!). 이 밖의 수많은 동물들의 놀라운 신체 능력들을 보고 있으면, 인간의 얇은 팔다리와 빈약한 근육, 자그마한 몸통은(사실 전체 동물계에서 보면 인간은 작지 않은 편이다. 오히려 중~대형 동물에 가깝다) 자연에서 살아남기에는 너무나 연약한 육체로 보인다. 인간에게 더 뛰어난 운동 능력이라는 것이 있기는 할까?
스페셜리스트 vs 제너럴리스트
본 이야기에 앞서, 다른 동물들과 인간은 왜 그리도 다를까? 말을 빌리자면, 다른 동물들은 스페셜리스트인 반면 인간은 제너럴리스트가 되었다. 다른 동물들은 좁은 서식지(niche)에서만 살아남을 수 있지만, 인간은 이전 글에서 보았듯 아프리카에서 출발해 놀라울 만큼 빠른 시간 안에 전 지구로 퍼져나갔다(그림 1: 적도부터 남극까지, 바닷가부터 3천 미터 이상의 고산 지대까지 살고 있는 동물은 인간뿐이다). 펭귄을 열대 우림에 두거나, 침팬지를 페루의 고산 지대에 두거나, 보아뱀을 그린란드에 둔다고 생각해보자. 동물 학대라는 사실을 잠깐 접어두더라도, 이들은 그리 오래 살아남지 못할 것이다. 펭귄은 얼음장같이 차가운 바닷물을 막아줄 깃털 층을 가졌지 열을 방출하는 구조를 갖지 않았고, 침팬지는 열대우림의 나무 캐노피를 뛰노는 신체 구조를 가졌지 적은 산소에 적응하여 뛰어다니는 신체 구조를 갖지 않았다. 그러나 연약한 인간의 육체는 그렇게 한다. 지능과 도구, 그리고 협업이라는 매개체를 통해.


그럼에도 불구하고, 인간이 대부분의 동물들보다 뛰어난 두 가지의 운동 능력이 있다. 사실, 이러한 능력은 지능과 도구 그리고 협동과 합쳐져 인간을 탁월한 사냥꾼으로 만들었다. 어찌나 뛰어난 사냥꾼인지 이미 선사 시대부터 다량의 대형 포유류들을 대량학살한 흔적들이 발견되며, 인간이 약 13만 년 전 아프리카를 벗어나 타 대륙으로 진출하는 족족 그곳에 살고 있던 대형 포유류들이 멸종해 왔다(F. Smith et al., 2018, Science). 매머드, 스밀로돈, 글립토돈, 대형 원시 곰과 같은 온갖 멸종한 대형 동물들이 그들이며, 아메리카 대륙에 이주하여 남아 있던 말의 조상들도 인간이 멸종시켰다(그래서 아메리카 문명에는 말이 없었다-유럽 침략자들이 들여 오기 전까지). 인간의 어떠한 능력이 인간을 뛰어난 사냥꾼으로 만들었을까? 그 중 한 가지는 언뜻 보기에 대단치 않아 보이는 능력인 달리기다.
한 발자국 그리고 또 한 발자국
우리는 달릴 수 있다. 걷기와는 뚜렷히 구별되는 달리기를(미주 2). 달릴 때는 두 발이 모두 공중에 체류하는 시간이 있다는 점에서 걷기와는 구분되는데(미주 3), 인간은 이러한 달리기를 어릴 때부터 할 수 있으며(그리고 나이에 비교적 구애받지 않고: 영국의 Fauja Singh는 92세에 마라톤을 완주했다), 또한 매우 긴 거리를 달릴 수 있다. 바로 이 점에서 인간의 독특한 신체 능력이 나타난다. 인간은 긴 거리를 지치지 않고 달릴 수 있다. 말하자면 인간은 자연계에서 끔찍한 단거리 주자이지만, 엄청나게 뛰어난 장거리 주자다. 이것을 지구력 달리기endurance running 이라고 부르는데, 모든 근육의 힘을 쏟아부어 짧은 시간 폭발적으로 달리는 것이 아니라 몇십 분이고 몇 시간이고 끊임없이 달리는 운동을 지칭한다.
 그림 2. 1936년 베를린에서 열린 마라톤에 참가한 손기정 선수가 첫 번째로 들어오고 있다.
그림 2. 1936년 베를린에서 열린 마라톤에 참가한 손기정 선수가 첫 번째로 들어오고 있다.인간은 지구력 달리기의 엄청난 강자다. 대표적인 사례가 무엇이 있을까? 마라톤이다(그림 2). 그리스 근처의 마라톤이라는 도시에서 벌어진 그리스-페르시아의 전투에서 전령으로 일했던 페이디피데스를 기리는 의미에서 장거리 달리기 경주를 시작한 것이 그 기원이며(미주 4), 수많은 사람들이 참여하고 있다. 40킬로미터를 몇 시간이고 달리는 것은 처음에는 불가능한 영역으로 보일 지 몰라도, 인간은 달리기에 있어 선천적으로 뛰어난 능력을 가지고 있다. 나도 요즘에는 취미로 달리기를 가끔 하는데, 처음엔 5분 뛰기도 벅차지만 두세 달만 가볍게 연습하더라도 1시간 가량 쉼 없이 달릴 수 있게 된다. 그만큼 인간의 몸은 장거리 달리기에 적합하다.
 그림 3. 가장 긴 달리기 경주인 self transcendence race. 무려 5천 킬로미터를 달린다.
그림 3. 가장 긴 달리기 경주인 self transcendence race. 무려 5천 킬로미터를 달린다.심지어 인간의 한계를 시험하는 듯이 보이는 마라톤을 뛰어넘는 울트라마라톤이라는 종목도 존재하며, 여기서는 100킬로미터나 그 이상을 경주한다(100킬로미터쯤을 달리면, 한 번의 경주로 5킬로그램 이상의 체중이 줄어드는 경우도 잦다). 심지어 Self-Transcendence race 라는 경기에서는 40일간 매일 18시간씩 5천 킬로미터를 달린다(그림 3). 런던까지의 거리가 8900km 가량임을 생각해보면 엄청난 거리며, 지구 둘레의 1/8 을 달리는 셈이다.
인간은 어떻게 잘 달리는가?
지구상의 거의 어떤 생물도 이러한 달리기를 할 수는 없다. 치타는 고작 몇십 초를 뛰고 나면 완전히 탈진하여 더 이상 달릴 수 없게 되며, 시간의 차이는 있지만 가젤과 같은 동물들도 그렇다. 일부 개들은 (과거의 무리 사냥의 잔재로) 장거리를 달릴 수 있지만, 뜨거운 태양 아래서는 이러한 능력이 매우 제한받는다. 심지어는 아주 오랜 기간 탈것으로 이용된 말조차도 그렇다. 빠른 달리기에서는 말은 빠르게 지치며(미주 5), 몇십 킬로미터 이상의 장거리 달리기에서는 인간이 말을 이길 수 있다(인간 대 말 마라톤이라는 경기가 있는데, 2004년 인간이 첫 승리를 거두었다: 그림 4).
 그림 4. 인간과 말이 같이 경주하는 마라톤 대회. 터무니없어 보여도 장거리에서는 인간에게도 승리의 기회가 있다.
그림 4. 인간과 말이 같이 경주하는 마라톤 대회. 터무니없어 보여도 장거리에서는 인간에게도 승리의 기회가 있다.인간은 왜 이렇게 잘 달리는가? 그것은 우리의 신체 구조에서 뚜렷이 드러난다. 우리의 신체 구조는 달리기 좋게 설계되어 있다. 이족 보행이 달리기의 효율을 높였는지, 에너지 절약에 도움이 되었는지에 대해서는 수십 년간 아주 많은 논의가 이루어졌고 또 이루어지고 있는 주제이지만(일부 연구는 영장류에서의 4족 보행에 비해 인간의 2족 보행은 약 75%의 에너지를 절약한다는 것을 보였다), 학자들이 대부분 동의하는 것은 인간의 몸이 장거리 달리기에 아주 적합한 것이라는 사실이다. 그것도 전신과 허리를 사용해 용수철처럼 튀어 나가는 단거리가 아닌(치타처럼! 네 발 동물들은 이러한 방식을 이용해 놀랄 만한 순간 속력을 내지만 대신 지구력을 잃었다), 아주 오랫동안 꾸준히 일정한 속도로 달리는 지구력 달리기에 말이다.
 그림 5. 인간의 발에는 부드럽게 굽어진 세 개의 아치형 구조가 있다. 이 구조는 착지 시의 충격을 완화하고 저장했다가 다시 도약하는 힘을 준다.
그림 5. 인간의 발에는 부드럽게 굽어진 세 개의 아치형 구조가 있다. 이 구조는 착지 시의 충격을 완화하고 저장했다가 다시 도약하는 힘을 준다. 인간의 팔은 달릴 때의 반동을 상쇄하기에 아주 적합하며, 얇은 종아리와 작은 발가락 대비 두꺼운 허벅지와 엉덩이 근육은 달리기에 적합한 신체 구조다(잘 달리는 동물들을 보면, 신체의 말단은 얇고 가벼우며 신체의 중앙쪽 근육은 잘 발달해 있다: 말과 타조를 살펴보라. 돌림힘의 원리를 생각해 보면 당연한데, 무게가 회전축에서 멀리 위치할수록 다리를 움직이는 데 큰 힘이 들 것이다).
길쭉하게 뻗은 다리, 충격을 분산시켜주기 위한 튼튼한 척추와 골반 또한 그러하며, 특히나 발목 뒤의 아킬레스건과 발에 존재하는 세 개의 아치 구조는 아주 중요한 역할을 한다(그림 5). 이 구조물은 인대와 연골의 탄성을 이용해 땅을 딛는 충격을 저장했다가, 다시 강하게 튀어오를 수 있게 해 준다(그래서 이 아치가 발달하지 않은 평발은 달리기가 쉽지 않다). 연구에 따르면 이러한 방법을 통해 70퍼센트에 달하는 반동을 다시 이용할 수 있다고 하는데, 이러한 에너지의 저장이 불가능했다면 달리기는 에너지 수지가 전혀 맞지 않는 행동이었을 것이다.
이번 글에서는 인간이 가지는 두 가지 뛰어난 신체 능력 중 하나인 달리기에 대해 알아보았다. 이어지는 다음 글에서는, 달리기에 대한 세부 사항과 신체적 적응에 대해 약간 더 알아본 이후 인간을 뛰어난 사냥꾼으로 만든 두 번째 능력에 대해서 알아본다. 그것은 무엇일까? 힌트를 주자면, 인간의 스포츠와 밀접한 관련이 있는 것 중 하나다.
미주Endnote
미주 1. 낙타는 여러 생리학적 적응을 통해 이러한 놀라운 능력을 보여주지만, 그 중 흥미로운 것으로는 낙타의 적혈구가 있다. 인간의 것에 비해 낙타는 더 작고 날렵한 모양의 적혈구를 갖는데, 이는 수분을 잃어 혈액의 점도가 높아져도 혈관을 막지 않아 수분 손실에 적응하게 해 준다. 또한, 낙타는 200리터 이상의 물을 한 번에 마실 수 있는데, 이는 다른 동물에게 물 중독(water intoxication) 을 유도하기 충분한 양이다. 한번에 너무 많은 물을 마시면 혈액이 묽어지는데, 이러면 삼투압에 의해 적혈구가 펑펑 터지며(용혈 현상이라고 한다) 산소 공급이 되지 않아 죽는다. 낙타의 날렵한 적혈구는 이러한 강한 삼투압에 대항할 수 있다(아래 그림 참조).
좌측: 낙타의 적혈구. 우측: 인간의 적혈구. 낙타는 사막에의 적응을 위해 혈구까지 뜯어고쳤다.
좌측: 낙타의 적혈구. 우측: 인간의 적혈구. 낙타는 사막에의 적응을 위해 혈구까지 뜯어고쳤다.